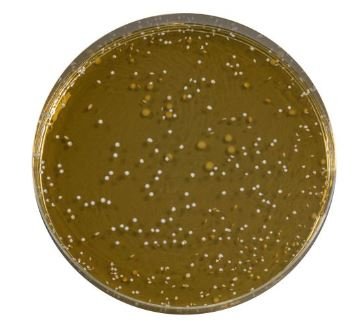
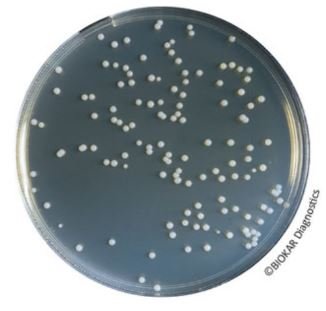
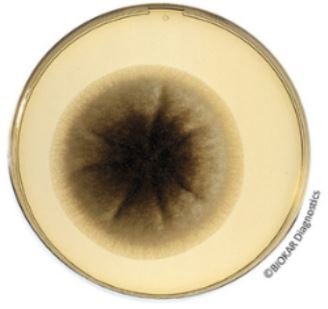
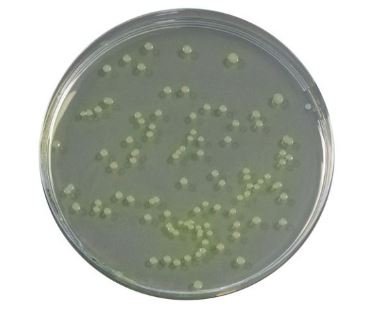
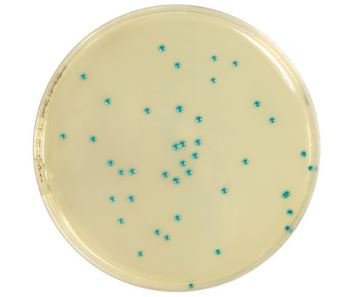

Food
- Animal Health
- Cosmetic
- Food
- Rapid methods
- Water and environments
- Presentation
- Microorganism

Modified Trypto-Casein Soy Broth (mTSB)

Modified Tryptone-Soy Broth (mTSB ) is an enrichment medium destined for the detection of pathogenic serotypes of E. coli, in particular the O157:H7 serotype, in food products and other potentially contaminated samples from animal origin.
Packaging
Dehydrated base medium (without novobiocin):
BK150HA – 500 g bottle
Novobiocin Selective Supplement:
BS05608 – 8 vials of 40 mg
BS03308 – 10 vials of 10 mg
MRS Agar
MRS Agar is used for the growth and enumeration of cultures of Lactobacillus in dairy and other food products as well as in products destined for animal feed.
The medium can be used to culture slowly-growing lactobacilli such as Lactobacillus brevis and Lactobacillus fermentum. Acidified to low pH, it can be used to enumerate Lactobacillus bulgaricus in yogurts.
According to the bacteria sought, the media can be adjusted in pH to obtain optimal growth.
Packaging
Ready-to-melt medium (pH 5,7) :
BM08908 – 10 vials of 200 mL
Dehydrated medium :
BK089HA – 500 g bottle
Pre-poured medium (pH5,7) :
BM23908 – 120 plates (Ø 90 mm)
MRS Broth

MRS Broth is used for the growth and enumeration of lactobacilli in food products. By transferring isolated colonies, luxuriant subcultures can be obtained. The medium can also be used to culture slowly-growing lactobacilli such as Lactobacillus brevis and Lactobacillus fermentum.
Packaging
Dehydrated medium :
BK070HA – 500 g bottle
MSE Agar (Mayeux, Sandine & Elliker)

This medium, developed by Mayeux, Sandine and Elliker in 1962, is an selective medium for the detection and enumeration of Leuconostoc in milk, dairy products and sweet foods.
Packaging
Dehydrated medium :
BK087HA – 500 g bottle
MSRV Medium

Modified Semi-Solid Rappaport-Vassiliadis Agar (MSRV) is a selective medium historically used for the isolation of Salmonella in chocolate and other food products. It is also widely used in animal health: in particular with mammals, poultry and in animal production facilities. It is also recommended for us in the detection of motile Salmonellae in animal fecal matter and in environmental samples in the context of primary animal production.
This medium is not recommended for immobile Salmonellae (Salmonella Gallinarum et Pullorum).
Packaging
Ready-to-melt medium:
BM12708 – 10 vials of 200 mL
Dehydrated medium:
BK191HA – 500 g bottle
Dehydrated base medium (without Novobiocin):
BK134HA – 500 g bottle
Novobiocin Selective Supplement:
BS03308 – 10 vials of 10 mg
BS05608 – 8 vials of 40 mg
MSRV Medium

Modified Semi-Solid Rappaport-Vassiliadis Agar (MSRV) is a selective medium historically used for the isolation of Salmonella in chocolate and other food products. It is also widely used in animal health: in particular with mammals, poultry and in animal production facilities. It is also recommended for us in the detection of motile Salmonellae in animal fecal matter and in environmental samples in the context of primary animal production.
This medium is not recommended for immobile Salmonellae (Salmonella Gallinarum et Pullorum).
Packaging
Ready-to-melt medium:
BM12708 – 10 vials of 200 mL
Dehydrated medium:
BK191HA – 500 g bottle
Dehydrated base medium (without Novobiocin):
BK134HA – 500 g bottle
Novobiocin Selective Supplement:
BS03308 – 10 vials of 10 mg
BS05608 – 8 vials of 40 mg
MUG 50 Mg Supplement

MUG 50 mg Supplement is used in selective media for the detection and enumeration of coliform bacteria in order to simultaneously detect E. coli in samples that may contain it: water, beverages, dairy products and other food products. It can be used in both liquid media (Laurylsulfate-Tryptose Broth) and in solid media (Violet Red Bile Agar, MacConkey agar…).
Packaging
Freeze-dried supplement:
BS02408 – 10 vials
Müller-Kauffmann Broth

Müller & Kauffmann Tetrathionate broth is one the oldest media traditionally used for the selective enrichment of Salmonella.
Packaging
Dehydrated base medium :
BK135HA – 500 g bottle
Novobiocin Selective Supplement :
BS03308 – 10 vials of 10 mg
BS05608 – 8 vials of 40 mg
Muller-Kauffmann Tetrathionate-Novobiocin Broth (MKTTn)

MKTTn Broth is used as one of two selective enrichment medium, along with RVS broth, for salmonellae in milk and dairy products and in other food products following the horizontal method described in the ISO 6579 standard. Associated with MSRV medium, it is also used in the protocol for the isolation and identification of Salmonella in animal production environments, in poultry and in mammals.
MKTTn broth is also used as a second selective enrichment broth for the detection of Salmonella in waters.
Packaging
Ready-to-use medium:
BM07808 – 50 tubes of 10 mL
Dehydrated medium (without iodine):
BK208HA – 500 g bottle
Dehydrated medium (without iodine nor Novobiocin):
BK169HA – 500 g bottle
Novobiocin Selective Supplement :
BS03308 – 10 vials of 10 mg
BS05608 – 8 vials of 40 mg
Muller-Kauffmann Tetrathionate-Novobiocin Broth (MKTTn)

MKTTn Broth is used as one of two selective enrichment medium, along with RVS broth, for salmonellae in milk and dairy products and in other food products following the horizontal method described in the ISO 6579 standard. Associated with MSRV medium, it is also used in the protocol for the isolation and identification of Salmonella in animal production environments, in poultry and in mammals.
MKTTn broth is also used as a second selective enrichment broth for the detection of Salmonella in waters.
Packaging
Ready-to-use medium:
BM07808 – 50 tubes of 10 mL
Dehydrated medium (without iodine):
BK208HA – 500 g bottle
Dehydrated medium (without iodine nor Novobiocin):
BK169HA – 500 g bottle
Novobiocin Selective Supplement :
BS03308 – 10 vials of 10 mg
BS05608 – 8 vials of 40 mg
Non-Animal MRS Broth

The Non-Animal version of MRS broth is used primarily for the growth of lactobacilli or lactic acid bacteria via industrial fermentation for use as starter cultures in varying food, cosmetic or pharmaceutical products. By substituting all animal peptones with non-animal equivalents, the regulatory and safety concerns arising from bovine spongiform encephalothopy and related pathologies can be successfully eliminated, making the medium an ideal fermentative formula providing excellent growth
Packaging
Dehydrated medium:
BK176HA – 500 g bottle
Novobiocin Selective Supplements

Novobiocin is used as a selective supplement in several applications :
– Muller Kauffmann, MKTTn broths, MSRV medium for the selective isolation of motile Salmonella.
– Modified casein-soy enrichment broth (mTSB) for the detection of E. coli O157.
Packaging
Freeze-dried supplement:
BS03308 – 10 vials of 10 mg
BS05608 – 8 vials of 40 mg
Nutrient Agar (2 %)

Nutrient agar at 2% is used in food microbiology, in water testing and in animal health for the culture of a wide variety of microorganisms. It is used for colony purification, a critical step in the protocols of identification in many standards. It is suitable for the culture of bacteria that have no particular nutritional requirements.
Packaging
Ready-to-melt medium:
BM11808 – 50 tubes of 18 mL
Dehydrated medium:
BK185HA – 500 g bottle
Of Glucose Agar

The OF Glucose agar allows the demonstration of glucose fermentation as an identification test for Enterobacteriaceae in the context of the following standards : NF EN ISO 21528-1 and NF EN ISO 21528-2 for the detection and enumeration of Enterobacteriaceae.
Packaging
Ready-to-use medium:
50 tubes of 10 mL – BM19708
Orange Serum Agar
Orange Serum Agar is used for the growth, isolation and enumeration of yeasts, molds and acid-tolerant bacteria (Bacillus, lactobacilli, Leuconostoc, Streptococcus, Clostridium), which are responsible for deteriorations in fruit juices and citrus concentrates. It has also been used for hygiene controls of industrial equipment used to prepare fruit-based beverages.
Packaging
Dehydrated medium :
BK103HA – 500 g bottle
Oxford Agar

Oxford Agar is a selective medium used for the differentiation, the isolation and the enumeration of Listeria monocytogenes from milk and cheese, as well as in other food samples, even highly contaminated.
The media can be used as the second media of choice in the context of the method of detection of Listeria monocytogenes in food microbiology.
Packaging
Dehydrated base medium :
BK110HA – 500 g bottle
CCCFA Supplement for Oxford agar :
BS00308 – 10 vials qsp 500 mL
Oxytetracycline Glucose Agar (OGA)
Oxytetracycline Glucose Agar is used for the detection and enumeration of yeasts and molds in food products.
The typical composition corresponds to that defined in the standards ISO 6611 and NF V08-059
Packaging
Ready-to-melt medium (without Oxytetracycline) :
BM02208 – 10 vials of 110 mL
Dehydrated medium (without Oxytetracycline):
BK053HA – 500 g bottle
BK053GC – 5 kg drum
Oxytetracycline 50 mg Supplement :
BS00808 – 10 vials
PALCAM Agar

PALCAM Agar is a selective medium used for the differentiation and isolation of Listeria monocytogenes and other Listeria, from milk and cheese, as well as in other food products, even highly contaminated.
The media can be used as a second media of choice in the context of the directives concerning the detection of Listeria monocytogenes in food microbiology.
PALCAM agar can also be used as a confirmation test for Listeria spp using the COMPASS® Listeria method.
Packaging
Ready-to-use medium:
BM02008 – 20 Petri plates Ø 90 mm
Dehydrated base medium:
BK145HA – 500 g bottle
PALCAM Selective Supplement:
BS00408 – 10 vials qsp 500 mL
BS04908 – 8 vials qsp 2,5 L
PCA With Skimmed Milk

Plate Count Agar with skimmed milk is used in food and dairy bacteriology to enumerate aerobic bacteria in milk powders and dairy products.
It is also used in the enumeration of psychrotrophic microorganisms.
Packaging
Ready-to-melt medium:
BM08608 – 10 vials of 200 mL
Dehydrated medium:
BK161HA – 500 g bottle
Penicillin And Pimaricin Agar (PPA)
Penicillin and Pimaricin Agar (PPA) is a selective medium for the enumeration of pigmented and non-pigmented psychrotophic Pseudomonas in milk, milk products and in dairy environment samples.
Packaging
Ready-to-use medium:
BM15608 – 20 Petri plates Ø 90 mm
Peptone Water

Peptone water is used for the culture of microorganisms with no particular growth requirements. This media is specifically used for the Mackenzie test for the identification of E. coli via indole production.
Packaging
Dehydrated medium :
BK084HA – 500 g bottle
Peptone Water 0,1 %

Peptone Water 0,1 % is one of the general use diluents used in the preparation of stock solutions of milk and dairy products according to ISO 6887-5 and for water analysis according to the standard NF EN ISO 8199.
This solution is also used as a specific diluent in the analysis of bivalve mollusks, gastropods and other marine shellfish, according to standard ISO 6887-3.
Packaging
Ready-to-use medium:
BM16408 – 2 flexible bags of 5 L
Plate Count Agar (PCA)

Plate Count Agar containing glucose and yeast extract is used in food bacteriology to enumerate aerobic bacteria in milk, meats, meat-based products, other food products, as well as for the analysis of pharmaceuticals, cosmetics and their associated raw materials.
It is also used for the enumeration psychrotrophic microorganisms.
Packaging
Ready-to-use medium :
BM21708 – 20 Petri plates Ø 90 mm
BM21808 – 120 Petri plates Ø 90 mm
Ready-to-melt medium:
BM01508 – 10 vials of 100 mL
BM03308 – 10 vials of 200 mL
Dehydrated medium:
BK144HA – 500 g bottle
BK144GC – 5 kg drum
Rappaport-Vassiliadis Soja (RVS) Broth

Rappaport-Vassiliadis Soja Broth is used for the selective enrichment of Salmonella in milk, dairy products, other food products, water and in environmental samples.
Packaging
Ready-to-use medium :
BM21708 – 20 Petri plates Ø 90 mm
BM21808 – 120 Petri plates Ø 90 mm
Ready-to-melt medium:
BM01508 – 10 vials of 100 mL
BM03308 – 10 vials of 200 mL
Dehydrated medium:
BK144HA – 500 g bottle
BK144GC – 5 kg drum
Reinforced Clostridial Agar

Reinforced Clostridial Agar is a non-selective medium used for the isolation and enumeration of Clostridia, other anaerobic bacteria and lactobacilli in biological samples, dairy products, and other food products.
Packaging
Dehydrated medium :
BK090HA – 500 g bottle
Reinforced Clostridial Medium

Reinforced Clostridial Medium is a non-selective medium used for the growth and enumeration of spores of total gas producing Clostridia in dairy products, canned foods, semi-preserved foods and other food products. It is also used for the detection of Clostridia in the microbiological examination of non-sterile products according to US and European Pharmacopeia.
Packaging
Dehydrated medium :
BK094HA – 500 g bottle
Rhapsody Agar®
RHAPSODY Agar® is a selective medium used for the enumeration of Pseudomonas spp. in food products and environmental samples.
This method is officially certified by AFNOR Certification for the enumeration of presumptive Pseudomonas spp. in meat products, in comparison to the reference method NF EN ISO 13720 : 2010, under the reference number BKR 23/09-05/15 A and in dairy products, in comparison to the reference method XP ISO/TS 11059 : 2009, under the reference number BKR 23/0905/15 B.
Packaging
Pre-poured medium:
BM16708 – 20 Petri plates Ø 90 mm
Dehydrated media:
BK214HA – 500 g bottle
RHAPSODY Selective Supplement:
BS08908 – 10 vials qsp 500 mL
Ringer’s Solution (1/4 Strength)
Ringer’s Solution 1/4 strength is a diluent used to prepare dispersion solutions for the microbiological control of water, milk, dairy and other food products. It is also widely used to prepare serial tenfold dilutions.
Packaging
Tablets:
BR00108 – 100 tablets bottle
Rogosa Agar

Rogosa Agar is a selective medium used for the enumeration of lactobacilli in meat, food products and biological samples of animal origin.
Given its high concentration in salts, the media is not adapted to the isolation of certain dairy lactobacilli such as Lactobacillus delbrueckii subsp. lactis or Lactobacillus delbrueckii subsp. bulgaricus.
Packaging
Dehydrated medium :
BK033HA – 500 g bottle
Salmonella Enrichment

Salmonella Enrichment is a special formulation of Buffered Peptone Water that has been created and controlled for optimal detection of Salmonella in food products and feed.
Salmonella Enrichment with Tween®80 is used as enrichment medium for Salmonella analysis of products whose fat content exceeds 20%.
Packaging
Ready-to-use medium:
BM13608- 10 vials of 225 mL
BM13708 – 3 flexible bags of 3 L
BM14408 – 2 flexible bags of 5 L
BM23708 – 40 flexible bags of 5 L
Dehydrated medium:
BK194HA – 500 g bottle
BK194CG – 5 kg drum
Ready-to-use medium + Tween® 80:
BM16308 – 3 flexible bags of 3 L
BM19808 – 2 flexible bags of 5 L
BM22808 – 10 x 225 mL vials
Salmonella Enrichment 9X Concentrated:
BM23308 – 4 x 2.5 L flexible bag